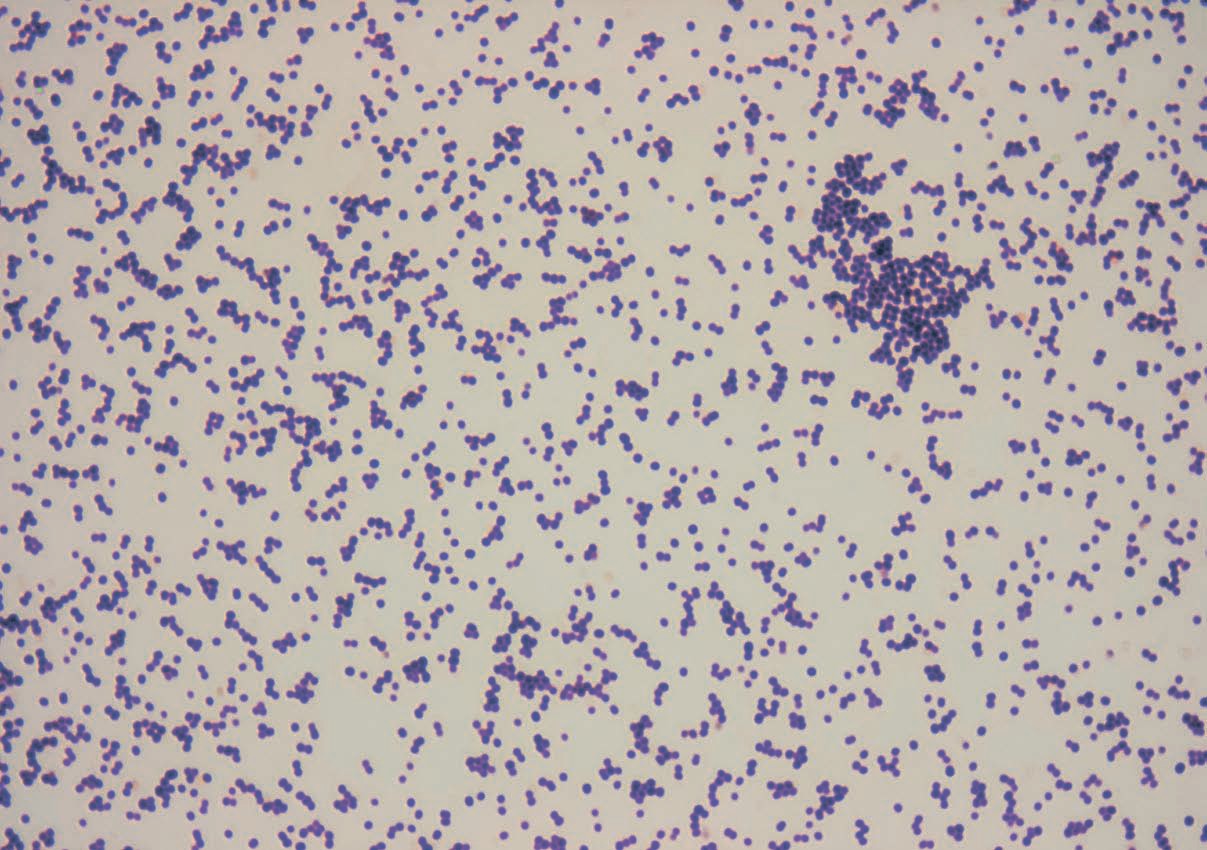

Новости науки

Солнечная система: Облака-озера и облака-айсберги
Недавно на Марсе нашли подледное озеро, вслед за тем водяной лед в больших количествах обнаружился на Луне, а теперь дошла очередь и до Юпитера. С помощью телескопов обсерватории Кека и инфракрасного телескопа IRTF, позволяющих заглянуть внутрь сверхплотной атмосферы планеты гиганта, астрофизики NASA изучили Большое Красное пятно — самый большой вихрь в Солнечной системе, намного превосходящий по размерам Землю. Оказалось, в нем много воды и кислорода, причем водяные облака там состоят не из водяного пара, а из жидкой воды или даже изо льда.
Виды: Мы с тобой одной крови
Эволюция человека — извилистая дорожка. Оказывается, например, что неандертальцев, денисовцев и Homo Sapiens, несмотря на существенные генетические различия, нельзя считать разными биологическими видами — все они являются предками современного человечества и в генетическом, и в культурном смысле. Разные популяции древних людей много контактировали, торговали и воевали друг с другом, обменивались опытом и заводили общих детей. Новое свидетельство этого появилось благодаря изучению находки археологов в Денисовой пещере: в 2016 году ученые обнаружили фрагмент кости человека, анализ ДНК которой показал, что она принадлежала дочке женщины-неандерталки и мужчины-денисовца. И хотя ученые предполагали, что такие смешанные союзы встречались, найденный фрагмент является первым в своем роде «вещественным доказательством» гипотезы.

Организм: Секрет Джоконды — ее болезнь
Около 1500 года Леонардо да Винчи написал одно из самых известных произведений мировой живописи — портрет Моны Лизы дель Джокондо. Фамилия модели словно определила, чем картина будет пленять: «Джоконда» в переводе с итальянского означает «веселая» — и вот уже полвека ее загадочная улыбка не дает покоя ученым. В ней читают нежность, гордость, кокетство и даже жестокость, но медики усмотрели… проблемы со здоровьем. Еще в 2004-м они предположили, что таинственный прищур итальянки вызван нарушением обмена жиров, а знаменитая улыбка — результат паралича лицевого нерва. Но сейчас врачи из Медицинской школы Гарварда и Университета Калифорнии пересмотрели диагноз — по последним данным, Мона Лиза страдала от недостатка гормонов щитовидной железы. Об этом говорят характерные для болезни желтоватый цвет лица, отсутствие бровей и сдвинутая назад линия волос. А Джоконда тем временем продолжает ухмыляться…

Гены: Завтракайте позже, ужинайте раньше
Появилось сразу два исследования, доказывающих, что сокращение интервала между первым и последним приемом пищи продлевает жизнь, улучшает метаболизм и способствует похуданию. В одном из них калифорнийские ученые отключили у мышей гены, отвечающие за поддержание циркадных ритмов, связанных со сменой дня и ночи. Нарушение этого цикла веет к многочисленным расстройствам. Одна группа этих мышей имела доступ к еде круглосуточно, другая — только в течение 10-часового промежутка, и если первая группа начала страдать от ожирения и разных болезней, то мыши из второй оставались здоровыми и не набрали веса. А британские ученые из Университета Суррея проверили на людях, как повлияет на ожирение отложенный на полтора часа завтрак и съеденный на полтора часа раньше ужин. Оказалось, это помогает снизить количество потребляемых калорий и долю жира в организме.
Комментарий: «Нам нужны технологии для поиска пропавших людей»
В рамках масштабного исследовательского проекта «Одиссея» идет прием заявок на первый в России технологический конкурс по созданию поисково-спасательных технологий нового поколения
Президент благотворительного фонда «Система» Анна Янчевская
«Одиссея» — всероссийский исследовательский проект, организованный фондом «Система» — состоит из серии конкурсов, задача которых в том, чтобы вовлечь энтузиастов в создание технологических решений для преодоления социальных проблем. Каждый конкурс проекта «Одиссея» посвящен одной проблеме. Тема первого конкурса — создание поисково-спасательных технологий нового поколения. Сейчас успех поисков пропавших людей во многом зависит от количества волонтеров и места пропажи: в среднем на поиски человека привлекается около 100 волонтеров, а наиболее сложной средой является густой лес. По-прежнему самым эффективным остается поиск с вертолета. Новые методы поиска, основанные на высокотехнологичных разработках, значительно повысят шансы найти пропавшего вовремя. Участники конкурса должны разработать технологию, которая поможет найти и вовремя спасти потерявшегося в лесу человека без источника связи в радиусе не менее 10 километров в течение 10 часов, при максимальном спектре погодных условий. Призовой фонд конкурса — 75 миллионов рублей.
Сбор заявок на участие продлится до 31 октября. На первых этапах конкурса участники познакомятся с поисково-спасательными отрядами и методами поиска, проведут исследование, после чего команды приступят к работе над прототипом. В финальном испытании в ноябре 2019 года командам предстоит продемонстрировать работу своих устройств на лесном полигоне, в условиях, максимально приближенным к реальным. По итогам конкурса мы ожидаем получить технологию, которая станет настоящим прорывом в поиске людей, поможет спасти тысячи жизней и может быть востребована всеми поисково-спасательными отрядами в России и других странах мира.
Цифра
7,7 см — на столько вырос уровень Мирового океана за последние 25 лет, по данным исследования World Climate Research Programme. Виной всему глобальное потепление: с каждым годом из-за теплового расширения воды и таяния льдов уровень океана поднимается на 3 миллиметра.
Схема: Я б в ученые пошел
В первом полугодии 2018 года средняя зарплата ученых, работающих в научных организациях, выросла в два раза по сравнению с аналогичным периодом прошлого года, по данным Росстата и НИУ ВШЭ. К такому результату привели мероприятия по повышению среднего уровня оплаты труда, проведенные в соответствии с президентским Указом.
Среднемесячная начисленная зарплата научных сотрудников, тыс. рублей

Фотография
Ученые из австралийского Института инфектологии и иммунитета обнаружили бактерию, устойчивую ко всем известным антибиотикам. Этот мутировавший штамм стафилококка, найденный в ходе исследования 78 больниц в 10 странах мира, появился из-за слишком частого использования новейших антибиотиков в больницах — бактерии успевают к ним приспособиться.
Фотографии: Gerald Eichstädt/Seán Doran/NASA/JPL-Caltech/SwRI/MSSS; Thilo Parg/ CC BY-SA 3.0; Леонардо да Винчи; из личного архива Анны Янчевской; Marc Perkins/CC BY-NC 2.0
Хочешь стать одним из более 100 000 пользователей, кто регулярно использует kiozk для получения новых знаний?
Не упусти главного с нашим telegram-каналом: https://kiozk.ru/s/voyrl
